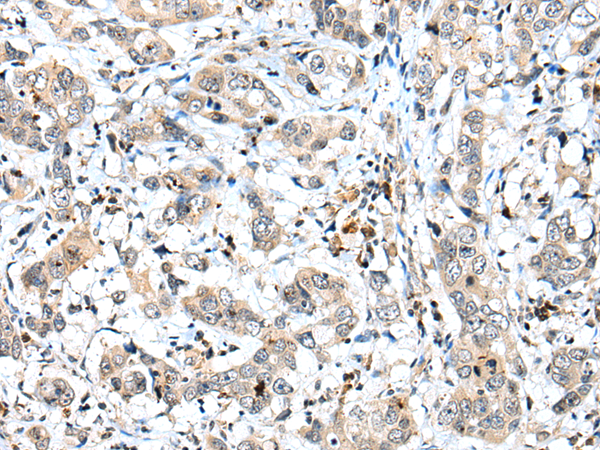

-
分类: 科研抗体货号: P09101别名: ACOT15应用: IHC反应种属: Human
-
分类: 科研抗体货号: P09102别名:应用: WB,IHC反应种属: Human, Mouse
-
分类: 科研抗体货号: P09118别名: MTH3应用: IHC反应种属: Human, Rat
-
分类: 科研抗体货号: P09100别名: PI31应用: WB,IHC反应种属: Human, Mouse, Rat
-
分类: 科研抗体货号: P09116别名: GFG1; GFG-1; ASFGF2; FGF-AS; FGF2AS应用: WB,IHC反应种属: Human, Mouse, Rat
-
分类: 科研抗体货号: P09099别名: CT79; TSA2; RSP44; TSGA2; RSPH10A应用: WB,IHC反应种属: Human
-
分类: 科研抗体货号: P09115别名: CPSF5; CFIM25应用: WB,IHC反应种属: Human, Mouse, Rat
-
分类: 科研抗体货号: P09098别名: LZP应用: IHC反应种属: Human, Mouse, Rat
-
分类: 科研抗体货号: P09113别名:应用: WB,IHC反应种属: Human, Mouse, Rat
-
分类: 科研抗体货号: P09097别名: SP1; CER2; COCO; CRL2; CERL2; DANTE; GREM3; CKTSF1B3应用: WB,IHC反应种属: Human

鄂公网安备42018502007531号
鄂公网安备42018502007531号

